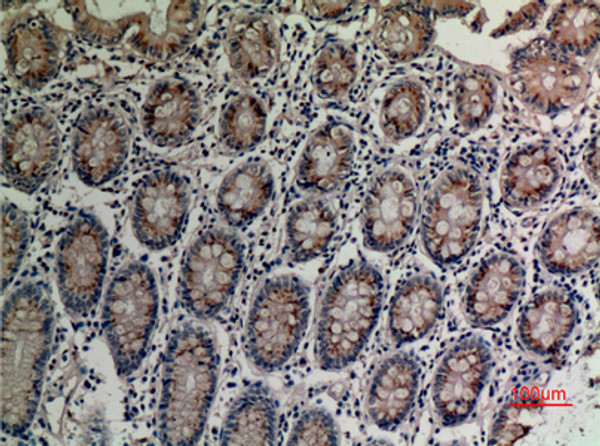
Immunohistochemical analysis of paraffin-embedded human-colon, antibody was diluted at 1:100 Immunohistochemical analysis of paraffin-embedded human-colon, antibody was diluted at 1:100

| Host: | Rabbit |
| Applications: | WB/IHC/IF/ELISA |
| Reactivity: | Human/Mouse |
| Note: | STRICTLY FOR FURTHER SCIENTIFIC RESEARCH USE ONLY (RUO). MUST NOT TO BE USED IN DIAGNOSTIC OR THERAPEUTIC APPLICATIONS. |
| Short Description : | Rabbit polyclonal antibody anti-Transient receptor potential cation channel subfamily V member 3 (Internal) is suitable for use in Western Blot, Immunohistochemistry, Immunofluorescence and ELISA research applications. |
| Clonality : | Polyclonal |
| Conjugation: | Unconjugated |
| Isotype: | IgG |
| Formulation: | Liquid in PBS containing 50% Glycerol, 0.5% BSA and 0.02% Sodium Azide. |
| Purification: | The antibody was affinity-purified from rabbit antiserum by affinity-chromatography using epitope-specific immunogen. |
| Concentration: | 1 mg/mL |
| Dilution Range: | WB 1:500-1:2000IHC-P 1:100-300ELISA 1:20000IF 1:50-200 |
| Storage Instruction: | Store at-20°C for up to 1 year from the date of receipt, and avoid repeat freeze-thaw cycles. |
| Gene Symbol: | TRPV3 |
| Gene ID: | 162514 |
| Uniprot ID: | TRPV3_HUMAN |
| Immunogen Region: | Internal |
| Specificity: | TRPV3 Polyclonal Antibody detects endogenous levels of TRPV3 protein. |
| Immunogen: | Synthesized peptide derived from the Internal region of human TRPV3. |
| Function | Non-selective calcium permeant cation channel. It is activated by innocuous (warm) temperatures and shows an increased response at noxious temperatures greater than 39 degrees Celsius. Activation exhibits an outward rectification. The channel pore can dilate to provide permeability to larger cations. May associate with TRPV1 and may modulate its activity. Is a negative regulator of hair growth and cycling: TRPV3-coupled signaling suppresses keratinocyte proliferation in hair follicles and induces apoptosis and premature hair follicle regression (catagen). |
| Protein Name | Transient Receptor Potential Cation Channel Subfamily V Member 3Trpv3Vanilloid Receptor-Like 3Vrl-3 |
| Database Links | Reactome: R-HSA-3295583 |
| Cellular Localisation | Cell MembraneMulti-Pass Membrane ProteinCytoplasmLysosomeTargeted To Lysosome For Degradation In A Snx11-Dependent Manner |
| Alternative Antibody Names | Anti-Transient Receptor Potential Cation Channel Subfamily V Member 3 antibodyAnti-Trpv3 antibodyAnti-Vanilloid Receptor-Like 3 antibodyAnti-Vrl-3 antibodyAnti-TRPV3 antibody |
Information sourced from Uniprot.org